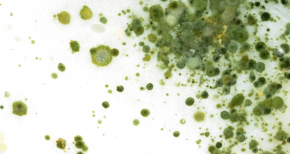

Agriculture
At SBR, we offer innovative solutions tailored to meet the evolving needs of the agricultural sector. Explore our range of products, designed to address specific challenges across various applications and support your product development goals.
Agrochemical Additives for Efficient Formulations
At SBR International, we specialize in providing high-quality additives that support the success of agrochemical formulators worldwide.
Our portfolio includes a wide range of surfactants, emulsifiers, and formulation enhancers sourced from leading global manufacturers. These ingredients are essential for developing effective solutions in crop protection and sustainable plant growth.
We offer additives designed to improve stability, coverage, and penetration under diverse climatic conditions, optimizing the performance of formulations such as EC, SC, SL, WP, WDG, EW, ME, OD and more…
Whether you’re formulating herbicides, fungicides, insecticides, fertilizers, or tank-mix adjuvants, our products ensure maximum efficacy, regulatory compliance, and technical support.
Thanks to our strategic partnerships with global producers, we deliver solutions that are safe, effective, and environmentally responsible.
Explore our dedicated categories for EC, SC, WP, WDG and more.